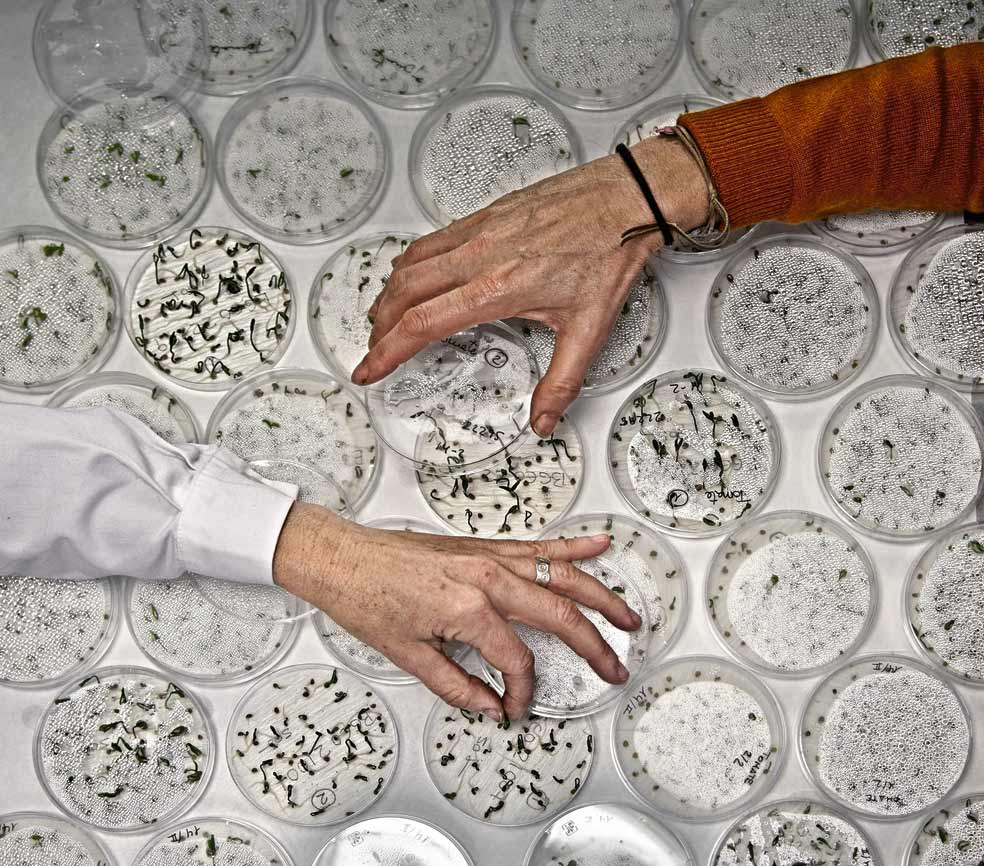
Los científicos comprueban la viabilidad de las semillas. Es importante que conserven su poder de germinación por si son necesarias en una emergencia agrícola. En Alcalá hay colecciones específicas de trigo, leguminosas, cebada y judías.

Le apetece una ensalada de oreja de mula? ¿Y un estofado de ombligos de reina? No se asuste, las orejas son una variedad de lechuga romana; y los ombligos, judías blancas con una mancha característica de color morado. Variedades autóctonas españolas cuyas simientes forman parte de nuestro patrimonio.
La humanidad lleva 13.000 años cultivando la tierra. A nuestros antepasados nadie les explicó lo que era la biodiversidad y, a pesar de ello, ... seleccionaban las semillas porque sobrevivían a las heladas, las sequías o las plagas; o porque daban alimentos que se conservaban o sabían mejor, y diferenciaban entre especies de tomates como el negro de Siberia y el amarillo bombilla.
Hoy en día, sin embargo, tras un último siglo desastroso para la biodiversidad, se ha perdido el 75 por ciento de las especies vegetales, según la FAO. La población es más vulnerable que nunca a los cambios del clima y dependiente de las grandes empresas que patentan las semillas.
La hambruna en Sudán del Sur es un recordatorio de nuestra fragilidad ante las catástrofes agrícolas. Y una bacteria conocida como 'el ébola de los olivos' lleva de cabeza a los aceiteros italianos. Dos ejemplos de que no tenemos garantía de que siempre habrá alimentos en el supermercado.
Somos previsibles. El 95 por ciento de nuestra dieta lo aportan 30 cultivos: arroz, maíz, trigo y patata a la cabeza. Así que los bancos de semillas son cada vez más importantes. Hay unos 1750 en todo el mundo, que albergan siete millones de muestras. El más conocido es la Bóveda Global de Svalbard, en Noruega, que pretende guardar copias de todas las semillas conocidas. Solo de trigo hay 150.000 variedades, 30.000 de maíz...

En España existen 37 bancos de semillas. El de referencia es el Centro Nacional de Recursos Fitogenéticos, en Alcalá de Henares (Madrid), que guarda duplicados de las colecciones de las comunidades autónomas, universidades y otros organismos.
Allí está todo lo que alguna vez se cultivó en nuestros campos, por ejemplo, legumbres casi extintas como la almorta, a la que Goya dedicó un grabado. Además de formar parte de nuestro patrimonio cultural y económico, una de estas humildes semillas podría salvarnos en caso de una catástrofe climática o una plaga.

Las muestras están a disposición del público y pueden ser solicitadas por agricultores y asociaciones. En Svalbard, sin embargo, la gestión es más parecida a la de un depósito bancario y solo el titular puede reclamarla. La única vez que esto ha sucedido fue a petición de investigadores de Siria, en 2015, que recuperaron muestras de trigo, cebada y pastos de un banco de semillas de Alepo destruido por los bombardeos y trasladado a Beirut.
En paralelo, agricultores jóvenes están recuperando variedades y 'liberando' las semillas como si fuera software de código abierto y, de paso, aprendiendo a mirar el paisaje con los ojos de nuestros abuelos. Laura Aceituno –experta en agroarqueología– explica: «Las hierbas en la orilla del camino ya no son malas hierbas, sino medicinas, alimentos, herramientas o juegos. Algunas flores nos evocan canciones y, cuando queremos sembrar esto o aquello, recordamos un refrán». Pan para hoy... y también para mañana.
Más de 
En otros medios
Esta funcionalidad es exclusiva para suscriptores.
Reporta un error en esta noticia